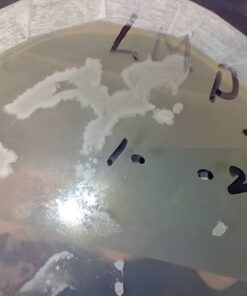
81XqiREUcL

Malt Extract Agar (MEA) 56 grams
Description
HIGHEST QUALITY LABORATORY GRADE MEA AVAILABLE Malt Extract Agar (perfect for
mushroom tissue cultures). A blend of high quality Malt Extract, Peptone G,
Beef Extract and cleanly processed Base Agar makes this an excellent mix for
mycelium growth. 56 grams will yield approximately 1 Liter of MEA Solution
which will yield 50, 100mm Petri Dishes at 20ml per dish. FORMULA: 35.7% Malt
Extract 1.8% Pancreatic Digest of Gelatin (Peptone G) 35.7% Dextrose 26.8%
Agar Agar SOLUTION INSTRUCTIONS: Step 1: Dissolve 56g of Malt Extract Agar
(MEA) in 1 Liter of Distilled Water Step 2: Bring to a Boil & Stir Step 3:
Autoclave at 121 degrees Celsius for 15 minutes Step 4: Pour into Petri Dishes
Features:
Product Details:
- Item Weight: 56 Grams
- Unit Count: 1.97 Ounce
- Number of Items: 1
- Package Weight: 0.06 Kilograms
- Item Form: Liquid
- Is Discontinued By Manufacturer : No
- Product Dimensions : 5 x 0.25 x 7 inches; 1.98 Ounces
- Item model number : SG_B008W7XHSU_US
- UPC :